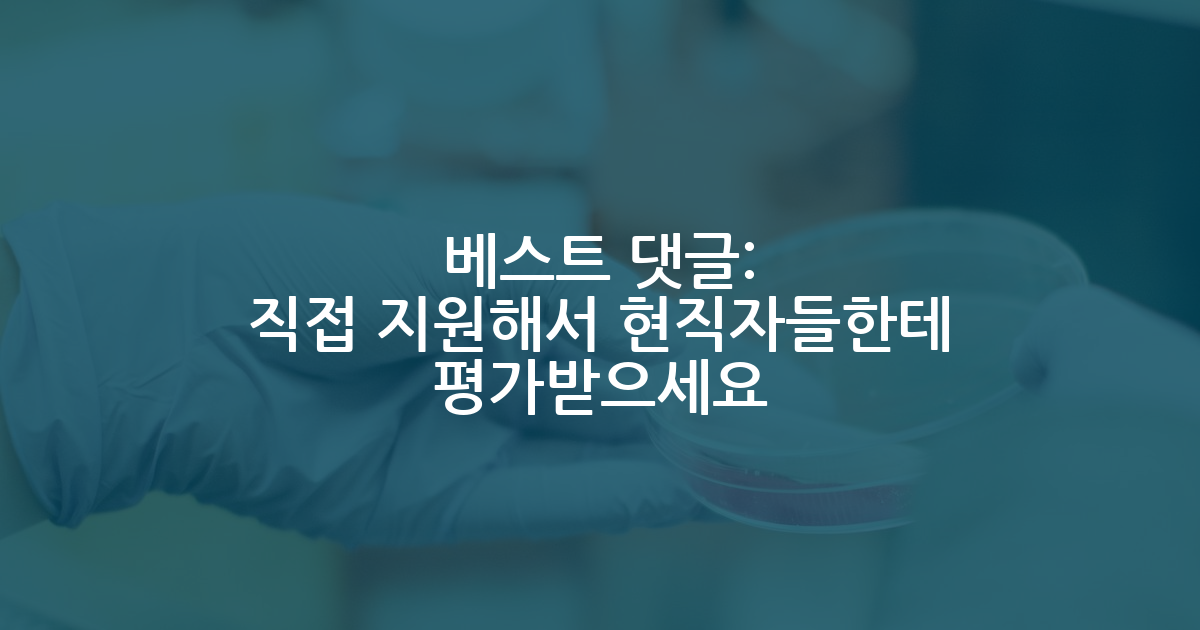

카카오 계정과 연동하여 게시글에 달린
댓글 알람, 소식등을 빠르게 받아보세요
가장 핫한 댓글은?
- 그정도는 본인이 알아서 하면 되는 일이겠지요?
연구실에 랩탑 들고 다니시는 분들
10 - 엥? 이걸 물어보는게 이상한데 보통 알아서 하지 않나요?
연구실에 랩탑 들고 다니시는 분들
13 - 댓글 왤케 날카롭게들 답변함? 글쓴이가 컴터랑 안 친해서 뭐 어떻게 해야할지 아예 모를수도 있지.
걍 모니터 암 사다가 원하는대로 배치하고, 노트북에 모니터 포트 수 부족하면 USB (모니터 포트) 변환기 검색해서 usb 에 꽃고 연결하면 됨.
모니터 암은 찾아보면 노트북 받침대도 파는게 있으니 적당히 잘 생각해서 사면 되고.
연구실에 랩탑 들고 다니시는 분들
15 - 남들보다 3배, 4배 시간을 투자하세요. 모든걸 기록하고 확실하게 알 때까지 질문하세요. 그런 시간이 반복되다 보면 나아집니다. 주변에 보면 성인 ADHD있어도 다들 잘만 박사하더이다.
연구에 재능이 없습니다
5 - 오해하고 계신게있는데
미국 포닥 후 교수되는 비율과 그렇지 못하는 비율을 잠깐 고민해보신다면 잘 풀리지 않을 가능성이 훨씬 높습니다.
mit stanford harvard 등등 내놓으라하는 대학들 가보시면 한국인 포닥들 바글바글합니다 박사과정분들까지 하면 더하구요.
댓글의 요지는 그런걸 신경쓰지 말고 갈길 가라는 말씀드립니다. 어차피 교수하고싶으시니 남들 큰돈 벌때 개의치않고 미국가시는거잖아요. 힘내십쇼
미국 포닥 절망편
11 - 교수하고 싶다는 내용은 본글에 없는데요?
미국 포닥 절망편
6 - 되면 하는게 아니라 되도록 만드는 것이 포닥입니다.
그 아무리 미국의 좋은곳으로 포닥 가더라도 거기서 살아남지 못하면 아무것도 못합니다. 다만 거기서 살아남기 위해 노력하다보면 의외의 기회가 정말 많이 생깁니다.
미국 포닥 절망편
7 - 계속 그리 못 간다고 생각하셈
지방사립4년제다니다가 건동홍 기계과로 일반편입했는데요
11 - 굳이 정보드러내고싶지않지만 uiuc 대학원에 MIT/하버드 중 한군데에서 포닥했고요. 뭐 하버드 포닥을 굳이 말하시는게 HMS말하시는건지 모르겠는데 평가를 잘해준다는건 어떤뜻인지 모르겠네요. UIUC/Gatech만해도 충분히 거기포닥하고 spk임용된 경우 많습니다. 예전에 로저스있던 시절에는 더더욱 많았고, 최근에도 종종 보입니다. 기회는 잡기 나름이라고 하시는데 궁금한게 본인은 어디 졸업하셔서 어디에서 잡을 잡으셨나요? 한국학계는 실적이 동일하면 MIT를 선호할지모르지만, 어차피 이미 UIUC/오스틴정도면 상향평준화됐고 뭐 '포닥'을 MIT/하버드나왔다고 가산점을 주는경우는 없습니다. 보스턴에 계셨는지 모르겠지만, 보스턴 내에서 한인포닥들 도움을 운운하시는게 좀 웃기네요. UIUC/오스틴만해도 한인포닥들 정말 많고 네트워킹 꽤나 괜찮은 편입니다. 저도 구체적으로 말은 못하지만 한인교회를 오래다녀서 네트워킹이 넓은편인데, 잡 잡는과정에서 박사과정이든 포닥이든 하면서 한인네트워킹 도움받은건 솔직히 크게 없었습니다. 포닥기관을 본인 학력이라 생각하는게 죄송하지만 좀 웃긴것같습니다.
미국 포닥 간판도 중요한가요?
6 - 김박사넷 분위기가 이럼. 무슨 글쓴이 지도교수에 빙의해서 '그런건 학생이 알아서 하면 되겠죠?' 이럼. 인터넷 속에서라도 권위적인 사람이 되고싶나봄. 현실은 본인은 글쓴이 지도교수도 아닌데.
설령 댓글들이 교수더라도 글쓴이가 교수인 님들을 딱 지목해서 물어본거겠어? 이런거 물어볼수도 있지
연구실에 랩탑 들고 다니시는 분들
8 - 일단 진짜로 그러한가와 관계없이 자기객관화를 해보려고 노력한다는 점에서 평균이상입니다. 과연 내가 연구에 자질이 있는 사람인가 고민하는 것 자체가 남다른 점이 있는 것이니 자기비하적으로 스스로를 깍아내릴 필요는 없습니다. 그리고 어려움을 극복하는 과정은 모두 다르기 때문에 왕도는 없습니다만 저는 전공분야보다 오히려 타전공을 더잘해서 돌파구를 찾았습니다. 석사전공은 기계공학인데 오히려 통계학이 더 적성에 맞았고 결국 통계 머신러닝을 취미처럼 해왔던게 큰 도움이 되었습니다. 취미처럼 할수있는 공부를 찾아보시고 선택과목으로 강의도 들어보세요. 저는 의대까지 가서 머신러닝강의를 들었습니다. 학점은 박살났지만 그때공부가 큰 자산이 되었습니다. 실험스킬은 경험많은 사람이 최고입니다. 실패하면 밤새서라도 다시 해보세요. 나중에는 눈감고도 합니다. 제가 느낀 석사과정은 잘 정의된 문제에 연구실의 유무형자원을 이용해 나의 방법론을 첨가하여 다시 풀어보는 시간이었습니다. 지금처럼 진지한 고민을 계속하신다면 글쓴이만의 아이디어가 분명히 생겨날 것입니다.
연구에 재능이 없습니다
6 - 비교좀 그만하세요. 동기들이 잘하면 좀 어떤가요?
자꾸 남하고 나하고 비교하면 인생 힘들어집니다.
연구하시면 안되는 이유가 있다면 님이 못해서가 아니라 그런식으로 남보다 못한점을 발견하여 자신 비하하는 태도입니다.
남들보다 못할수 있다는거 인정하고 그냥 계속 죄송스럽게 행동하세요. 어차피 욕 좀 먹으면 어떻습니까? 학생인데. 욕하라고 하세요.
다만 님이 나중에 님같은분 만나면 자기비하하듯 비하하지말고 도와주세요. 그러면 됩니다.
연구에 재능이 없습니다
6 - 교수는 제 때 졸업시켜주고 인건비만 안 떼먹으면 존나 좋은 교수입니다.
욕하고, 차별하고, 기분파에 지도를 안 하고, 지랄염병을 해도 졸업을 잘 시켜준다면 그냥 견디세요.
그리고 박사과정이라면 교수의 지도는 어디까지나 짬 많이 먹은 사람의 조언에 불과합니다. 지도가 있던 없던 큰 상관이 없어야 해요. 자기 주제에 관한건 교수를 이겨먹을 수 있어야 박사 타이틀을 따는 겁니다. 자기 연구주제에 대해 내가 교수보다 더 잘 아는데, 교수가 지도를 안 해줘도 그게 뭐 큰 대수일까요?
피해야 하는 연구실 리스트
14
석사 실적 평가 부탁드립니다.
2025.10.15
현재 SCI 2편 있고 하나는 1저자 하나는 2저자 입니다.
프로젝트 참가 경험은,
2024 CES 모 회사의 프로젝트에 참여해서 자율주행 시스템 개발
모 중소기업 실외 로봇 개발(이게 SCI 2저자) 사업
한국자동차연구원과 자율주행 버스 개발 사업
자율주행 실증 프로젝트 참여
이정도 입니다.
참고로 어렸을때 해외유학 경험있어서 토익은 공부없이 800넘기고 스피킹은 외국인와 문제없이 의사소통 되는 정도입니다.
다만 학부 학점이 3.1로 쫌 낮고 석사 학점은 4.0입니다.
HL클레무브 혹은 그정도 회사를 목표로 하고있습니다.
자율주행관련 랩실 문의 김GPT 1 11 13100-
0 21 4501 -
1 1 939
자율주행 랩 관련 질문입니다. 김GPT 7 6 3509
대학원 진학 문의 김GPT 1 4 5966-
0 5 980 -
1 2 1994
S대 자율주행 ㅇㄱㅅ교수님 어떠신가요 김GPT 0 2 7565-
0 14 4895 -
144 36 113838 -
445 70 56174
슬픈 국내 AI의 현실 명예의전당 149 39 53761
베스트 최신 글
- 공저자 싫은데.. 어쩔수 없이 하게 되는 분위기라면
3257 - 연구에 재능이 없습니다
4169 - 미국 포닥 절망편
9642 - 학술석사인데 M.E.를 받았습니다.
3858 - 제가 했던 활동들이 각 연구실에게 예의가 아닐까요...?
5088 - 연구실에 랩탑 들고 다니시는 분들
6132 - 자연어처리 학회 수준
6860 - 카이스트 김재철AI 대학원 박사 월급 관련
6804 - 대학원생 연애 상담
5056 - 학부 2점대 박사 진학..
6340
베스트 최신 글
🔥 시선집중 핫한 인기글
- 미국 현 대학교수의 관점에서 본 미국유학
42 - 합격하는 SOP는 무엇이 다른가?
5 - 미국 현 대학교수의 관점에서 본 미국유학 (블로그 글 10개)
17 - 서카포 자대생 인식
134 - 박사는 누가 하나.
35 - 연구실 고를 때 몇 가지 위험신호들
69 - (우울주의) 실패에 대하여
174 - 석사 때 탑컨퍼 쓰고 나가시는 분들 넘 부럽네요
9 - 수학과 학부생 인공지능 대학원?
3 - 학사 석사 박사의 학교와 학위가 전부 다른건 어떻게 생각하시나요?
5 - 어떻게 벌써 자퇴생이 발생하냐 ㅋㅋㅋㅋㅋ
4 - 피해야 하는 연구실 리스트
23 - 미국 포닥 지원 후기
7
최근 댓글이 많이 달린 글
- 석사까지 하려던 랩실을 떠나야할지, 남아야할지 모르겠습니다.
10 - [무료] 2026 미국 대학원 유학 준비 스타터팩 이벤트
105 - 지금까지 인터뷰 연락 없음 끝이라고 봐야겟죠
11 - AI PhD 미박 질문 (UMich)
49 - 컴퓨터 아키텍처/EDA 분야 다이렉트 PhD 지원 현실적으로 어느 정도까지 가능할까요?
16 - 미국 AI 대학원 유학 가능성
9 - 미국 포닥 절망편
14 - 공저자 싫은데.. 어쩔수 없이 하게 되는 분위기라면
11 - 석사생 분들 모르는 학부생에게 조언 메일 오면 어떨 것 같으신가요?
6 - 발표 공포증 극복은 어떻게 해야할까요?
9 - 석박통합 지원 후 석사 전환
8 - 둘 중 누가 더 취업에 유리할까요?
8 - 사실 과기원 중 위치선정최악은 디지임
7

2025.10.15
대댓글 1개
2025.10.15
대댓글 1개
2025.10.16
대댓글 1개
2025.10.16
대댓글 1개